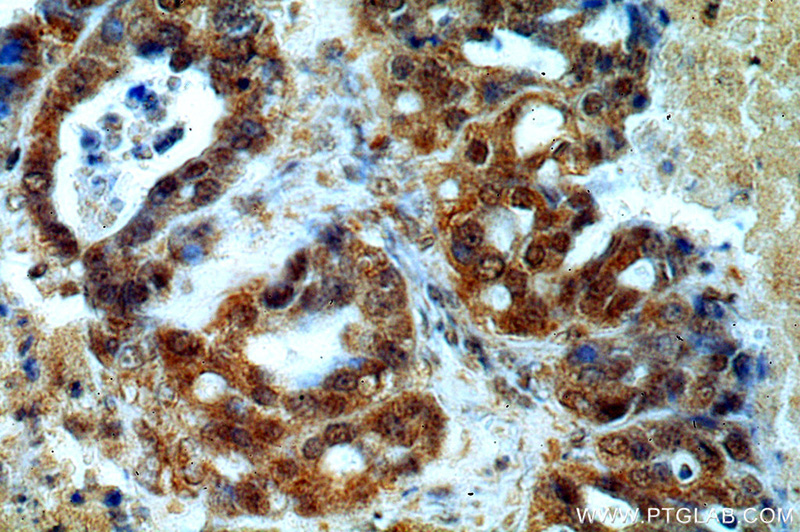
Immunohistochemical of paraffin-embedded human ovary tumor using Catalog No:107454(PAX8 antibody) at dilution of 1:50 (under 40x lens)

-
Product Name
PAX8 antibody
- Documents
-
Description
PAX8 Mouse Monoclonal antibody. Positive IHC detected in human ovary tumor. Positive WB detected in Hepg2 cells. Observed molecular weight by Western-blot: 48kd
-
Tested applications
ELISA, WB, IHC
-
Species reactivity
human; other species not tested.
-
Alternative names
PAX8 antibody; paired box 8 antibody; Paired box protein Pax 8 antibody
-
Isotype
Mouse IgG2b
-
Preparation
This antibody was obtained by immunization of PAX8 recombinant protein (Accession Number: NM_003466). Purification method: Protein A purified.
-
Clonality
Monoclonal
-
Formulation
PBS with 0.1% sodium azide and 50% glycerol pH 7.3.
-
Storage instructions
Store at -20℃. DO NOT ALIQUOT
-
Applications
Recommended Dilution:
WB: 1:200-1:2000
IHC: 1:20-1:200
-
Validations

HepG2 cells were subjected to SDS PAGE followed by western blot with Catalog No:107454(PAX8 antibody) at dilution of 1:200

Immunohistochemical of paraffin-embedded human ovary tumor using Catalog No:107454(PAX8 antibody) at dilution of 1:50 (under 10x lens)
Immunohistochemical of paraffin-embedded human ovary tumor using Catalog No:107454(PAX8 antibody) at dilution of 1:50 (under 40x lens)
-
Background
PAX8 is a member of the paired box (PAX) family of transcription factors, typically containing a paired box domain and a paired-type homeodomain. It is expressed during organogenesis of the thyroid gland, kidney and Mullerian system. It is thought to regulate the expression of Wilms tumor suppressor (WT1) gene and mutations in PAX8 have been associated with Wilms tumor cells, thyroid and ovarian carcinomas. PAX8 is a useful marker in distinguishing ovarian carcinomas from mammary carcinomas (PMID: 18724243). PAX8 is expressed in a high percentage of ovarian serous, endometrioid, and clear cell carcinomas, but only rarely in primary ovarian mucinous adenocarcinomas. PAX8 has 5 isoforms with calculated MW 31kd, 34kd, 41kd, 43kd and 48kd. And there is a 60kd band corresponding to the electrophoretic mobility of PAX8 (PMID:15650356).
Related Products / Services
Please note: All products are "FOR RESEARCH USE ONLY AND ARE NOT INTENDED FOR DIAGNOSTIC OR THERAPEUTIC USE"
